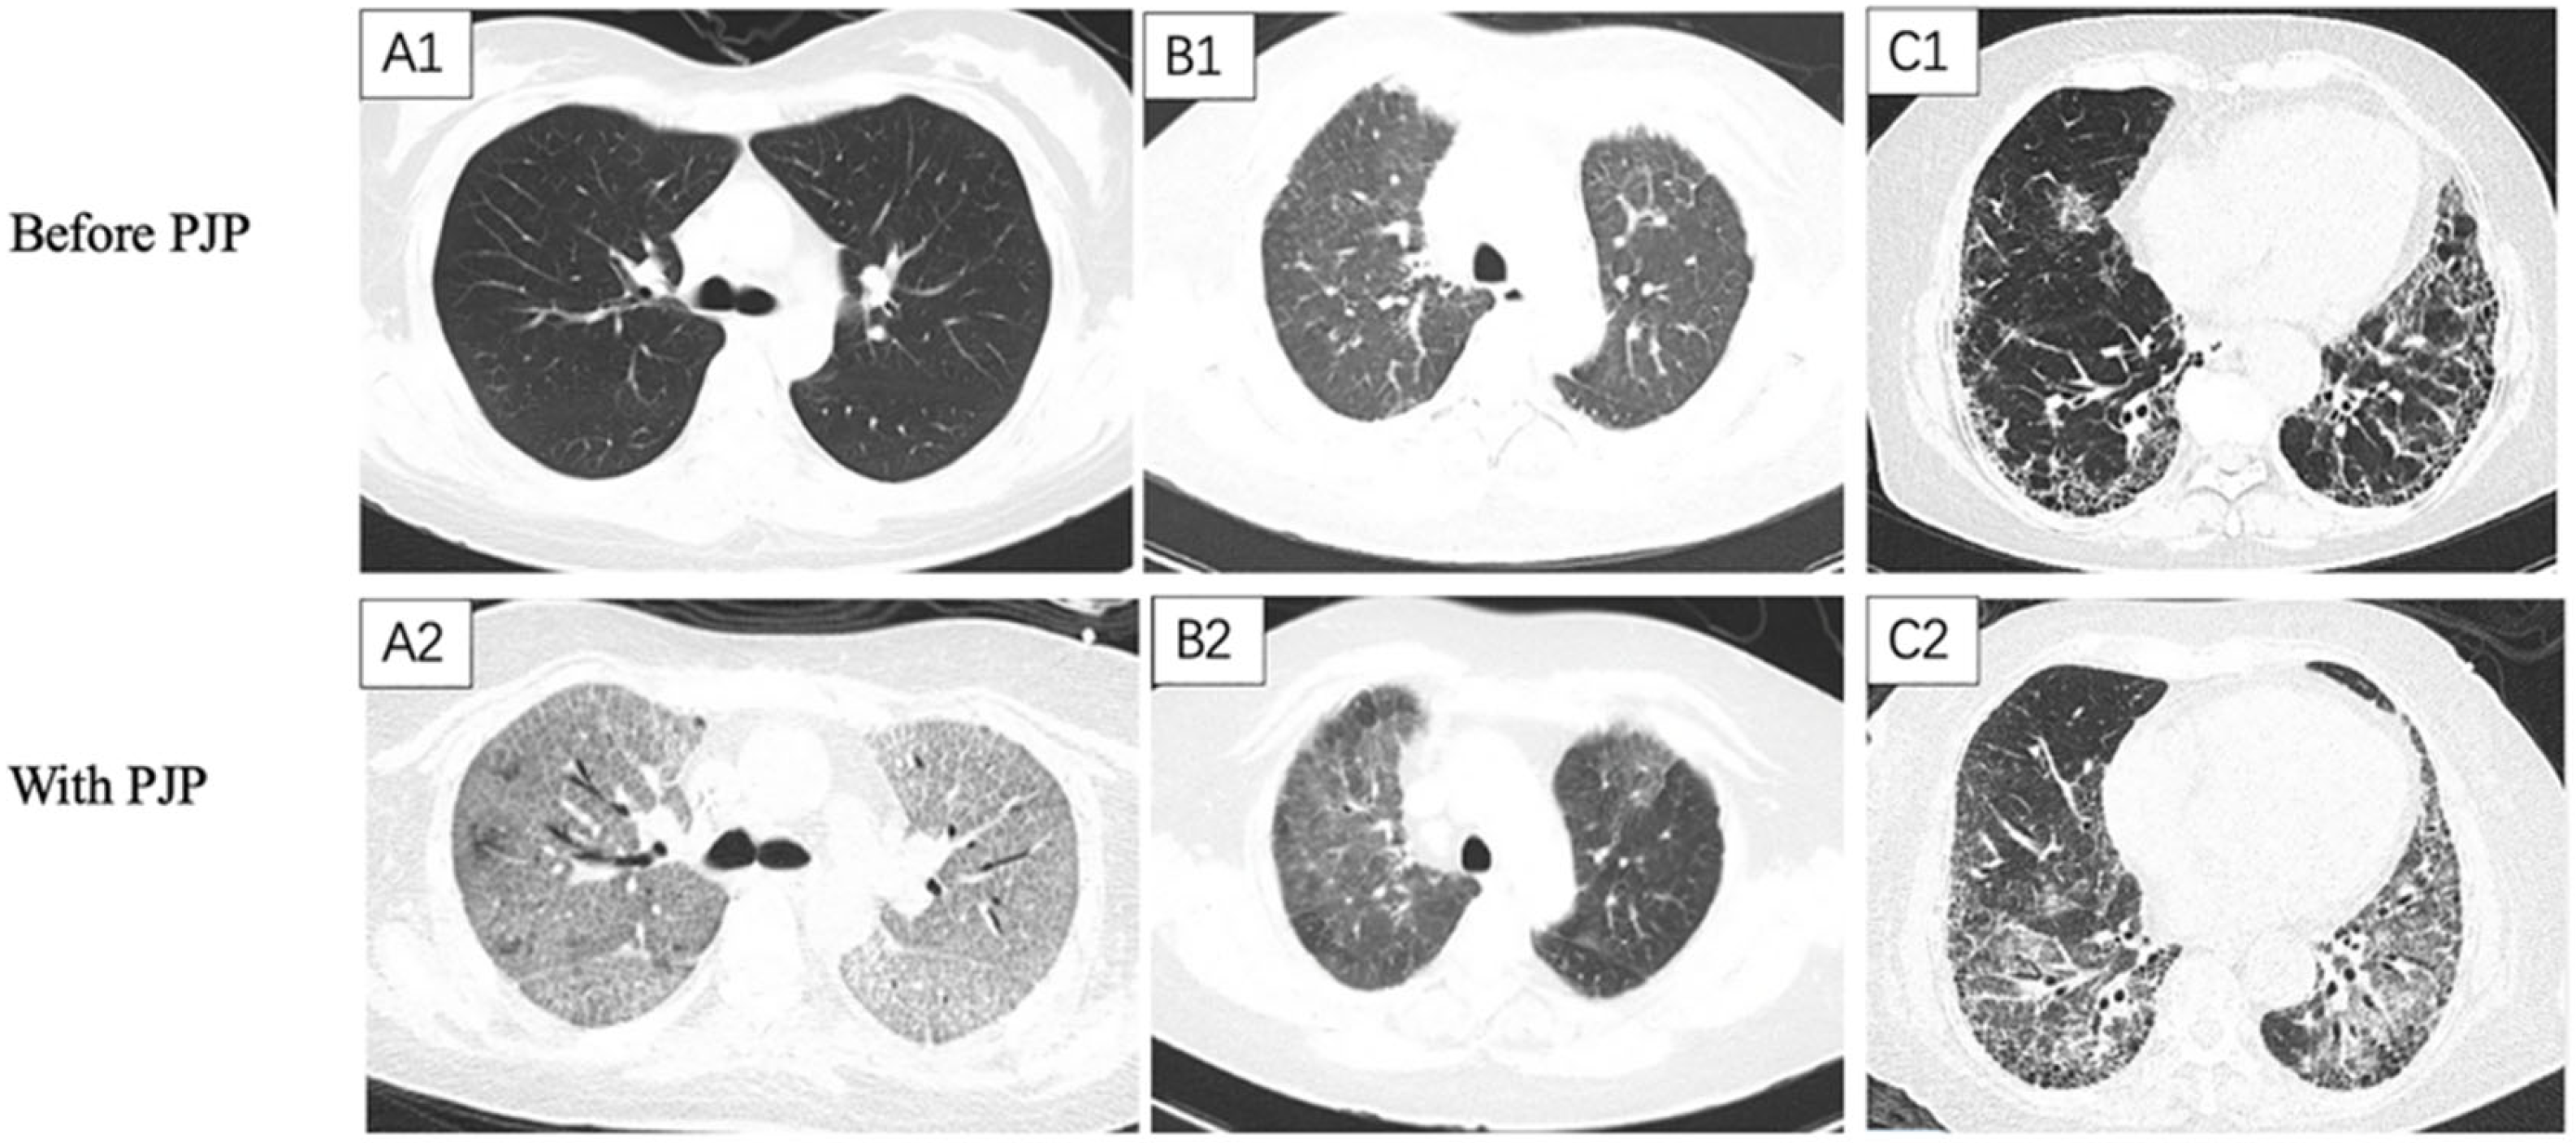

Prognostic Analysis of Pneumocystis Jirovecii Pneumonia in Interstitial Lung Disease Patients: A Retrospective Clinical Study
Abstract
1. Introduction
2. Materials and Methods
3. Statistical Analysis
4. Results
4.1. General Characteristics of the Enrolled PJP Patients
4.2. ILD-PJP vs. Non-ILD-PJP
4.3. FILD-PJP vs. Non-FILD-PJP
5. Discussion
6. Conclusions
Author Contributions
Funding
Institutional Review Board Statement
Informed Consent Statement
Data Availability Statement
Acknowledgments
Conflicts of Interest
References
- Bienvenu, A.-L.; Traore, K.; Plekhanova, I.; Bouchrik, M.; Bossard, C.; Picot, S. Pneumocystis pneumonia suspected cases in 604 non-HIV and HIV patients. Int. J. Infect. Dis. 2016, 46, 11–17. [Google Scholar] [CrossRef] [PubMed]
- Inoue, N.; Fushimi, K. Adjunctive Corticosteroids decreased the risk of mortality of non-HIV Pneumocystis Pneumonia. Int. J. Infect. Dis. 2019, 79, 109–115. [Google Scholar] [CrossRef]
- Schmidt, J.J.; Lueck, C.; Ziesing, S.; Stoll, M.; Haller, H.; Gottlieb, J.; Eder, M.; Welte, T.; Hoeper, M.M.; Scherag, A.; et al. Clinical course, treatment and outcome of Pneumocystis pneumonia in immunocompromised adults: A retrospective analysis over 17 years. Crit. Care 2018, 22, 307. [Google Scholar] [CrossRef] [PubMed]
- Yu, Q.; Jia, P.; Su, L.; Zhao, H.; Que, C. Outcomes and prognostic factors of non-HIV patients with pneumocystis jirovecii pneumonia and pulmonary CMV co-infection: A Retrospective Cohort Study. BMC Infect. Dis. 2017, 17, 392. [Google Scholar] [CrossRef] [PubMed]
- Wang, Y.; Zhou, X.; Saimi, M.; Huang, X.; Sun, T.; Fan, G.; Zhan, Q. Risk Factors of Mortality From Pneumocystis Pneumonia in Non-HIV Patients: A Meta-Analysis. Front. Public Health 2021, 9, 680108. [Google Scholar] [CrossRef] [PubMed]
- Weng, L.; Huang, X.; Chen, L.; Feng, L.Q.; Jiang, W.; Hu, X.Y.; Wang, C.-Y.; Zhan, Q.-Y.; Du, B. Prognostic factors for severe Pneumocystis jirovecii pneumonia of non-HIV patients in intensive care unit: A bicentric retrospective study. BMC Infect. Dis. 2016, 16, 528. [Google Scholar] [CrossRef]
- Ricciardi, A.; Gentilotti, E.; Coppola, L.; Maffongelli, G.; Cerva, C.; Malagnino, V.; Mari, A.; Di Veroli, A.; Berrilli, F.; Apice, F.; et al. Infectious disease ward admission positively influences P. jiroveci pneumonia (PjP) outcome: A retrospective analysis of 116 HIV-positive and HIV-negative immunocompromised patients. PLoS ONE 2017, 12, e0176881. [Google Scholar] [CrossRef] [PubMed]
- Hamada, S.; Ichiyasu, H.; Inaba, M.; Takahashi, H.; Sadamatsu, T.; Akaike, K.; Masunaga, A.; Tashiro, Y.; Hirata, N.; Yoshinaga, T.; et al. Prognostic impact of pre-existing interstitial lung disease in non-HIV patients with Pneumocystis pneumonia. ERJ Open Res. 2020, 6, 00306-2019. [Google Scholar] [CrossRef]
- Ishikawa, Y.; Nakano, K.; Tokutsu, K.; Miyata, H.; Fujino, Y.; Matsuda, S.; Tanaka, Y. Estimation of treatment and prognostic factors of pneumocystis pneumonia in patients with connective tissue diseases. RMD Open 2021, 7, e001508. [Google Scholar] [CrossRef]
- Ghembaza, A.; Vautier, M.; Cacoub, P.; Pourcher, V.; Saadoun, D. Risk Factors and Prevention of Pneumocystis jirovecii Pneumonia in Patients With Autoimmune and Inflammatory Diseases. Chest 2020, 158, 2232–2332. [Google Scholar] [CrossRef]
- Vidal, S.; de la Horra, C.; Martín, J.; Montes-Cano, M.A.; Rodríguez, E.; Respaldiza, N.; Varela, J.M.; Medrano, F.; Calderon, E. Pneumocystis jirovecii colonisation in patients with interstitial lung disease. Clin. Microbiol. Infect. 2006, 12, 231–235. [Google Scholar] [CrossRef]
- Bergin, C.J.; Wirth, R.L.; Berry, G.J.; Castellino, R.A. Pneumocystis carinii pneumonia: CT and HRCT observations. J. Comput. Assist. Tomogr. 1990, 14, 756–759. [Google Scholar] [CrossRef]
- Vogel, M.; Vatlach, M.; Weissgerber, P.; Goeppert, B.; Claussen, C.; Hetzel, J.; Horger, M. HRCT-features of Pneumocystis jiroveci pneumonia and their evolution before and after treatment in non-HIV immunocompromised patients. Eur. J. Radiol. 2012, 81, 1315–1320. [Google Scholar] [CrossRef]
- Oikonomou, A.; Prassopoulos, P. Mimics in chest disease: Interstitial opacities. Insights Imaging 2012, 4, 9–27. [Google Scholar] [CrossRef]
- Cereser, L.; Dallorto, A.; Candoni, A.; Volpetti, S.; Righi, E.; Zuiani, C.; Girometti, R. Pneumocystis jirovecii pneumonia at chest High-resolution Computed Tomography (HRCT) in non-HIV immunocompromised patients: Spectrum of findings and mimickers. Eur. J. Radiol. 2019, 116, 116–127. [Google Scholar] [CrossRef]
- Orlandi, M.; Landini, N.; Sambataro, G.; Nardi, C.; Tofani, L.; Bruni, C.; Randone, S.B.; Blagojevic, J.; Melchiorre, D.; Hughes, M.; et al. The role of chest CT in deciphering interstitial lung involvement: Systemic sclerosis versus COVID-19. Rheumatology 2022, 61, 1600–1609. [Google Scholar] [CrossRef] [PubMed]
- Ruaro, B.; Baratella, E.; Confalonieri, P.; Wade, B.; Marrocchio, C.; Geri, P.; Busca, A.; Pozzan, R.; Andrisano, A.G.; Cova, M.A.; et al. High-Resolution Computed Tomography: Lights and Shadows in Improving Care for SSc-ILD Patients. Diagnostics 2021, 11, 1960. [Google Scholar] [CrossRef]
- Li, M.-C.; Lee, N.-Y.; Lee, C.-C.; Lee, H.-C.; Chang, C.-M.; Ko, W.-C. Pneumocystis jiroveci pneumonia in immunocompromised patients: Delayed diagnosis and poor outcomes in non-HIV-infected individuals. J. Microbiol. Immunol. Infect. 2014, 47, 42–47. [Google Scholar] [CrossRef] [PubMed]
- Raghu, G.; Remy-Jardin, M.; Richeldi, L.; Thomson, C.C.; Inoue, Y.; Johkoh, T.; Kreuter, M.; Lynch, D.A.; Maher, T.M.; Martinez, F.J.; et al. Idiopathic Pulmonary Fibrosis (an Update) and Progressive Pulmonary Fibrosis in Adults: An Official ATS/ERS/JRS/ALAT Clinical Practice Guideline. Am. J. Respir. Crit. Care Med. 2022, 205, e18–e47. [Google Scholar] [CrossRef] [PubMed]
- Raghu, G.; Remy-Jardin, M.; Myers, J.L.; Richeldi, L.; Ryerson, C.J.; Lederer, D.J.; Behr, J.; Cottin, V.; Danoff, S.K.; Morell, F.; et al. Diagnosis of Idiopathic Pulmonary Fibrosis. An Official ATS/ERS/JRS/ALAT Clinical Practice Guideline. Am. J. Respir. Crit. Care Med. 2018, 198, e44–e68. [Google Scholar] [CrossRef] [PubMed]
- Raghu, G.; Remy-Jardin, M.; Ryerson, C.J.; Myers, J.L.; Kreuter, M.; Vasakova, M.; Bargagli, E.; Chung, J.H.; Collins, B.F.; Bendstrup, E.; et al. Diagnosis of Hypersensitivity Pneumonitis in Adults. An Official ATS/JRS/ALAT Clinical Practice Guideline. Am. J. Respir. Crit. Care Med. 2020, 202, e36–e69. [Google Scholar] [CrossRef]
- Donnelly, J.P.; Chen, S.C.; Kauffman, C.A.; Steinbach, W.J.; Baddley, J.W.; Verweij, P.E.; Clancy, C.J.; Wingard, J.R.; Lockhart, S.R.; Groll, A.H.; et al. Revision and Update of the Consensus Definitions of Invasive Fungal Disease From the European Organization for Research and Treatment of Cancer and the Mycoses Study Group Education and Research Consortium. Clin. Infect. Dis. 2020, 71, 1367–1376. [Google Scholar] [CrossRef]
- Kumagai, S.; Arita, M.; Koyama, T.; Kumazawa, T.; Inoue, D.; Nakagawa, A.; Kaji, Y.; Furuta, K.; Fukui, M.; Tomii, K.; et al. Prognostic significance of crazy paving ground grass opacities in non-HIV Pneumocystis jirovecii pneumonia: An observational cohort study. BMC Pulm. Med. 2019, 19, 47. [Google Scholar] [CrossRef]
- Yoshida, A.; Kamata, N.; Yamada, A.; Yokoyama, Y.; Omori, T.; Fujii, T.; Hayashi, R.; Kinjo, T.; Matsui, A.; Fukata, N.; et al. Risk Factors for Mortality in Pneumocystis jirovecii Pneumonia in Patients with Inflammatory Bowel Disease. Inflamm. Intest. Dis. 2018, 3, 167–172. [Google Scholar] [CrossRef]
- Chen, M.; Tian, X.; Qin, F.; Zhou, J.; Liu, J.; Wang, M.; Xu, K.-F. Pneumocystis Pneumonia in Patients with Autoimmune Diseases: A Retrospective Study Focused on Clinical Characteristics and Prognostic Factors Related to Death. PLoS ONE 2015, 10, e0139144. [Google Scholar] [CrossRef] [PubMed]
- Aman, J.; van der Heijden, M.; van Lingen, A.; Girbes, A.R.; van Nieuw Amerongen, G.P.; van Hinsbergh, V.W.; Groeneveld, A.J. Plasma protein levels are markers of pulmonary vascular permeability and degree of lung injury in critically ill patients with or at risk for acute lung injury/acute respiratory distress syndrome. Crit. Care Med. 2011, 39, 89–97. [Google Scholar] [CrossRef] [PubMed]
- Lee, S.H.; Huh, K.H.; Joo, D.J.; Kim, M.S.; Kim, S.; Lee, J.; Park, M.S.; Kim, Y.S.; Kim, S.K.; Chang, J.; et al. Risk factors for Pneumocystis jirovecii pneumonia (PJP) in kidney transplantation recipients. Sci. Rep. 2017, 7, 1571. [Google Scholar] [CrossRef]
- Li, Y.; Ghannoum, M.; Deng, C.; Gao, Y.; Zhu, H.; Yu, X.; Lavergne, V. Pneumocystis pneumonia in patients with inflammatory or autoimmune diseases: Usefulness of lymphocyte subtyping. Int. J. Infect. Dis. 2017, 57, 108–115. [Google Scholar] [CrossRef]
- Yang, L.; Xia, P.; Zhou, Y.; Cui, Q.; Chen, G.; Zheng, K.; Qin, Y.; Li, X. Characteristics and risk factors for Pneumocystis jirovecii pneumonia in patients with idiopathic membranous nephropathy. Eur. J. Clin. Microbiol. Infect. Dis. 2021, 40, 2305–2314. [Google Scholar] [CrossRef] [PubMed]
- Mecoli, C.A.; Saylor, D.; Gelber, A.C.; Christopher-Stine, L. Pneumocystis jiroveci pneumonia in rheumatic disease: A 20-year single-centre experience. Clin. Exp. Rheumatol. 2017, 35, 671–673. [Google Scholar]
- Zhang, Y.; Zheng, Y. Pneumocystis jirovecii pneumonia in mycophenolate mofetil-treated patients with connective tissue disease: Analysis of 17 cases. Rheumatol. Int. 2014, 34, 1765–1771. [Google Scholar] [CrossRef] [PubMed]
- Stern, A.; Green, H.; Paul, M.; Vidal, L.; Leibovici, L. Prophylaxis for Pneumocystis pneumonia (PCP) in non-HIV immunocompromised patients. Cochrane Database Syst. Rev. 2014, 2014, CD005590. [Google Scholar] [CrossRef] [PubMed]
- Avino, L.J.; Naylor, S.M.; Roecker, A.M. Pneumocystis jirovecii Pneumonia in the non-HIV-infected population. Ann. Pharmacother. 2016, 50, 673–679. [Google Scholar] [CrossRef] [PubMed]
- De Benedetti, E.; Nicod, L.P.; Reber, G.; Vifian, C.; De Moerloose, P. Procoagulant and fibrinolytic activities in bronchoalveolar fluid of HIV-positive and HIV-negative patients. Eur. Respir. J. 1992, 5, 411–417. [Google Scholar] [CrossRef]
- Wang, M.; Dong, X.; Huang, Y.; Su, J.; Dai, X.; Guo, Y.; Hu, C.; Zhou, Q.; Zhu, B. Activation of the kynurenine pathway is associated with poor outcome in Pneumocystis pneumonia patients infected with HIV: Results of 2 months cohort study. BMC Infect. Dis. 2019, 19, 223. [Google Scholar] [CrossRef]
- Wool, G.D.; Miller, J.L. The Impact of COVID-19 Disease on Platelets and Coagulation. Pathobiology 2020, 88, 15–27. [Google Scholar] [CrossRef]
- Rostami, M.; Mansouritorghabeh, H. D-dimer level in COVID-19 infection: A systematic review. Expert Rev. Hematol. 2020, 13, 1265–1275. [Google Scholar] [CrossRef]
- Travis, W.D.; Costabel, U.; Hansell, D.M.; King, T.E., Jr.; Lynch, D.A.; Nicholson, A.G.; Ryerson, C.J.; Ryu, J.H.; Selman, M.; Wells, A.U.; et al. An official American Thoracic Society/European Respiratory Society statement: Update of the international multidisciplinary classification of the idiopathic interstitial pneumonias. Am. J. Respir. Crit. Care Med. 2013, 188, 713–748. [Google Scholar] [CrossRef]
- Kim, T.-O.; Lee, J.-K.; Kwon, Y.-S.; Kim, Y.-I.; Lim, S.-C.; Kim, M.-S.; Kho, B.G.; Park, C.-K.; Oh, I.-J.; Kim, Y.-C.; et al. Clinical characteristics and prognosis of patients with Pneumocystis jirovecii pneumonia without a compromised illness. PLoS ONE 2021, 16, e0246296. [Google Scholar] [CrossRef]
- Matsumura, Y.; Shindo, Y.; Iinuma, Y.; Yamamoto, M.; Shirano, M.; Matsushima, A.; Nagao, M.; Ito, Y.; Takakura, S.; Hasegawa, Y.; et al. Clinical characteristics of Pneumocystis pneumonia in non-HIV patients and prognostic factors including microbiological genotypes. BMC Infect. Dis. 2011, 11, 76. [Google Scholar] [CrossRef]

| Underlying disease (n = 374) |
| Connective tissue diseases (CTDs, n = 184) |
| Systemic vasculitis (n = 48) |
| Systemic lupus erythematosus (n = 45) |
| Idiopathic inflammatory myositis (n = 40) |
| Rheumatoid arthritis (n = 17) |
| Primary Sjögren syndrome (n = 12) |
| Other kinds of CTDs (n = 22) |
| Kidney diseases (n = 59) |
| Primary glomerulonephritis (n = 56) |
| Renal failure (n = 3) |
| Malignancies (n = 58) |
| Hematological malignancy (n = 33) |
| Other malignancy (n = 25) |
| Pulmonary diseases (n = 28) |
| Idiopathic interstitial pneumonia (n = 24) |
| Emphysema (n = 3) |
| Sarcoidosis (n = 1) |
| Non-malignant hematological diseases (n = 18) |
| Dermatologic diseases (n = 13) |
| Neurological diseases (n = 4) |
| Transplantations (n = 4) |
| Endocrinologic diseases (n = 3) |
| Inflammatory bowel diseases (n = 2) |
| Severe drug-induced liver injury (n = 1) |
| Variables | ILD-PJP (n = 133) | Non-ILD-PJP (n = 245) | t or χ2 | p Value |
|---|---|---|---|---|
| Age (mean ± SD)y | 54.1 ± 16.3 | 63.2 ± 9.6 | 4.17 | <0.001 |
| Gender (male, n/%) | 67/50.4% | 105/42.9% | 1.97 | 0.16 |
| Glucocorticosteroids before PJP (n/%) | 99/74.4% | 211/86.1% | 7.98 | <0.01 |
| Prednisone (>1 mg/kg/d) | 99/76.7% | 167/72.9% | 0.63 | 0.43 |
| Methylprednisolone (>500 mg/d) | 29/21.8% | 29/11.8% | 6.59 | 0.01 |
| Respiratory failure (n/%) | 114/85.7% | 172/70.2% | 6.54 | 0.01 |
| Ventilation (n/%) | ||||
| Invasive ventilation | 60/45.1% | 109/44.5% | 0.01 | 0.91 |
| Non-invasive ventilation | 39/29.3% | 72/29.4% | 0.001 | 0.99 |
| ICU admission (n/%) | 65/48.9% | 127/51.8% | 0.3 | 0.58 |
| Pneumomediastinum (n/%) | 26/19.56% | 21/8.6% | 9.54 | <0.01 |
| Death during PJP (n/%) | 77/57.9% | 94/38.4% | 13.3 | <0.01 |
| Died from respiratory failure | 45/33.8% | 48/19.6% | 3.33 | <0.01 |
| CMV viremia | 76/57.1% | 134/54.7% | 0.21 | 0.65 |
| Laboratory tests | ||||
| WBC (109/L)(mean ± SD) | 14.3 ± 66.6 | 9.66 ± 20.1 | 0.79 | 0.44 |
| Lymphocyte (%) | 9.4 ± 7.8 | 11.7 ± 10.9 | 1.66 | 0.1 |
| Lymphocyte count (109/L)(mean ± SD) | 0.8 ± 0.8 | 0.9 ± 0.9 | 1.23 | 0.22 |
| ESR elevation (n/%) | 97/78.9% | 149/76% | 0.35 | 0.56 |
| hsCRP elevation (n/%) | 112/88.2% | 180/83.0% | 1.71 | 0.19 |
| LDH (U/L) (mean ± SD) | 614.4 ± 530 | 580.8 ± 351.0 | 0.75 | 0.46 |
| LDH elevation (n/%) | 120/94.5% | 206/90.4% | 1.86 | 0.17 |
| Hypo-immunoglobin G %(n/%) | 41/35.3% | 100/52.6% | 8.66 | 0.003 |
| D-dimer(mg/L) | 9.1 ± 21.8 | 7.9 ± 19.2 | 0.21 | 0.83 |
| Fbg(g/L) | 4.0 ± 1.9 | 4.3 ± 2.5 | 1.54 | 0.12 |
| βDG(pg/mL) | 692.5 ± 963.3 | 1129 ± 1266.7 | 4.47 | <0.001 |
| Chest HRCT features | ||||
| Sub-pleural distribution (n/%) | 68/51.3% | 48/19.6% | 40.3 | <0.001 |
| Peri-bronchial distribution (n/%) | 13/9.8% | 22/9.0% | 0.06 | 0.8 |
| GGO (n/%) | 106/79.7% | 176/71.8% | 2.81 | 0.09 |
| Consolidation (n/%) | 36/27.1% | 106/43.3% | 9.64 | 0.002 |
| Reticular (n/%) | 50/37.6% | 17/6.9% | 55.5 | <0.001 |
| Honeycomb (n/%) | 19/14.3% | 1/0.4% | 33.1 | <0.001 |
| Nodular (n/%) | 46/34.6% | 112/45.7% | 4.39 | 0.036 |
| Septal thickening (n/%) | 39/29.3% | 16/6.5% | 36.0 | <0.001 |
| Pleural thickening (n/%) | 92/69.2% | 120/49.0% | 14.3 | <0.001 |
| Pleural effusion (n/%) | 43/32.3% | 101/41.2% | 2.89 | 0.09 |
| Lymphadenopathy (n/%) | 79/59.4% | 97/39.6% | 13.6 | <0.001 |
| The interval between onset and diagnosis of PJP (days) | 31.1 ± 94.9 | 21.0 ± 75.1 | 1.98 | 0.047 |
| Variables | ILD-PJP (n = 111) | Non-ILD-PJP (n = 205) | t or χ2 Value | p Value |
|---|---|---|---|---|
| Ly count (×109/L) | 818.6 ± 2295.6 | 693.6 ± 695.3 | −0.27 | 0.79 |
| Lymphocytopenia (n/%) | 105/94.6% | 192/93.7% | 0.11 | 0.74 |
| B cell count * (×109/L) | 289.0 ± 2247.0 | 80.1 ± 115.1 | 0.2 | 0.84 |
| B lymphocytopenia * (n/%) | 97/90.7% | 173/91.1% | 0.01 | 0.91 |
| B cell percent * | 13.1 ± 14.3 | 11.7 ± 11.3 | 0.61 | 0.54 |
| Lower B cell percent * (n/%) | 51(47.7) | 98(51.3) | 0.36 | 0.55 |
| NK cell count # (×109/L) | 72.6 ± 128.2 | 64.9 ± 74.8 | −0.55 | 0.59 |
| NK lymphocytopenia # (n/%) | 100/91.7% | 182/92.4% | 0.04 | 0.84 |
| NK cell percent # | 13.8 ± 34.8 | 11.2 ± 9.9 | −0.46 | 0.65 |
| Lower NK cell percent # (n/%) | 64/58.7% | 108/54.6% | 0.5 | 0.48 |
| T cell count (×109/L) | 460.0 ± 449.4 | 546.0 ± 590.6 | −0.45 | 0.65 |
| T lymphocytopenia (n/%) | 106/95.5% | 185/90.2% | 2.73 | 0.1 |
| T cell percent | 75.1 ± 15.9 | 75.6 ± 14.5 | 0.11 | 0.91 |
| Lower T cell percent (n/%) | 20/18.0% | 38/18.5% | 0.01 | 0.93 |
| CD4+ T cell count (×109/L) | 197.5 ± 219.6 | 232.9 ± 281.8 | −0.58 | 0.57 |
| CD4+ T lymphocytopenia (n/%) | 104/93.7% | 184/89.8% | 1.38 | 0.24 |
| CD4+ T cell percent | 31.3 ± 15.9 | 40.2 ± 85.3 | −1.17 | 0.24 |
| Lower CD4+ T cell percent (n/%) | 58/52.3% | 98/47.6% | 0.63 | 0.43 |
| CD8+ T cell count (×109/L) | 236.9 ± 266.7 | 277.3 ± 353.8 | −0.53 | 0.60 |
| CD8+ T lymphocytopenia (n/%) | 92/82.9% | 160/78.1% | 1.04 | 0.31 |
| CD8+ T cell percent | 40.2 ± 18.4 | 43.5 ± 41.1 | 0.05 | 0.96 |
| Lower CD8+ T cell percent (n/%) | 13/11.7% | 24/11.7% | 0 | 0.99 |
| CD4+ T/CD8+ T | 1.3 ± 1.7 | 1.2 ± 1.1 | −0.68 | 0.50 |
| Variables | Univariable Analysis | Multivariable Analysis | ||||||
|---|---|---|---|---|---|---|---|---|
| χ2 | p | OR | 95% CI | χ2 | p | OR | 95% CI | |
| ICU admission | 27.7 | <0.001 | 3.69 | 2.27, 6.0 | ||||
| With diabetes | 6.64 | 0.01 | 0.51 | 0.3, 0.85 | ||||
| Pneumomediastinum | 5.05 | 0.02 | 1.79 | 1.08, 2.96 | ||||
| With aspergillosis | 8.36 | 0.001 | 2.40 | 1.42, 4.06 | ||||
| With HAP | 13.2 | <0.001 | 2.32 | 1.47, 3.66 | ||||
| Respiratory failure | 8.36 | 0.004 | 4.44 | 1.62, 12.2 | ||||
| Invasive ventilation | 36.1 | <0.001 | 4.40 | 2.72,7.15 | ||||
| Non-invasive ventilation | 23.3 | <0.001 | 3.07 | 1.95, 4.85 | 7.33 | 0.007 | 928.6 | 6.59, 130,796.5 |
| Lymphocyte count | 5.19 | 0.02 | 0.62 | 0.41, 0.93 | ||||
| Lymphocyte % | 9.74 | 0.002 | 0.94 | 0.90, 0.98 | ||||
| Minimal albumin | 17.3 | <0.001 | 0.94 | 0.91, 0.97 | ||||
| Ferritin elevation | 4.20 | 0.04 | 4.45 | 1.07,18.51 | ||||
| D-dimer | 10.7 | 0.001 | 1.01 | 1.01,1.02 | 10.9 | <0.001 | 1.2 | 1.08, 1.34 |
| D-dimer elevation | 8.21 | 0.004 | 3.41 | 1.47, 7.87 | ||||
| hsCRP | 6.49 | 0.01 | 1.004 | 1.001, 1.007 | ||||
| Lymphocytopenia | 4.98 | 0.026 | 1.94 | 1.08, 3.46 | ||||
| CD4+ T lymphocytopenia | 4.82 | 0.03 | 1.78 | 1.06, 2.97 | ||||
| CD8+ T lymphocytopenia | 5.12 | 0.02 | 2.22 | 1.11, 4.42 | ||||
| Caspofungin | 15.4 | <0.001 | 2.51 | 1.59, 3.98 | ||||
| Clindamycin | 5.38 | 0.02 | 1.83 | 1.1, 3.07 | ||||
| Primaquine | 4.21 | 0.04 | 2.62 | 1.05, 6.56 | ||||
| Variables | FILD-PJP (n = 70) | Non-FILD-PJP (n = 63) | t or χ2 Value | p Value |
|---|---|---|---|---|
| Age (y) | 63.2 ± 9.5 | 54 ± 16.2 | −3.1 | 0.002 |
| Diabetes mellitus (n/%) | 30/42.9% | 14/22.2% | 6.4 | 0.01 |
| Invasive ventilation (n/%) | 25/35.7% | 35/55.6% | 5.3 | 0.02 |
| Non-invasive ventilation (n/%) | 26/37.1% | 13/20.6% | 4.4 | 0.04 |
| Hemoptysis (n/%) | 9/12.9% | 1/1.6% | 4.5 | 0.03 |
| LDH(U/L) | 589.1 ± 654.2 | 643.5 ± 337.8 | 2.5 | 0.01 |
| 1,3-β-D-glucan (βDG, pg/mL) | 592.1 ± 929.2 | 804.7 ± 995.9 | 2.6 | 0.01 |
| Elevated βDG (n/%) | 43/65.2% | 53/89.8% | 10.7 | 0.001 |
Publisher’s Note: MDPI stays neutral with regard to jurisdictional claims in published maps and institutional affiliations. |
© 2022 by the authors. Licensee MDPI, Basel, Switzerland. This article is an open access article distributed under the terms and conditions of the Creative Commons Attribution (CC BY) license (https://creativecommons.org/licenses/by/4.0/).
Share and Cite
Sun, Y.; Shao, C.; Huang, H.; Chen, R.; Xu, K.; Li, M.; Zhang, X.; Xu, Z. Prognostic Analysis of Pneumocystis Jirovecii Pneumonia in Interstitial Lung Disease Patients: A Retrospective Clinical Study. Diagnostics 2022, 12, 2925. https://doi.org/10.3390/diagnostics12122925
Sun Y, Shao C, Huang H, Chen R, Xu K, Li M, Zhang X, Xu Z. Prognostic Analysis of Pneumocystis Jirovecii Pneumonia in Interstitial Lung Disease Patients: A Retrospective Clinical Study. Diagnostics. 2022; 12(12):2925. https://doi.org/10.3390/diagnostics12122925
Chicago/Turabian StyleSun, Yuxin, Chi Shao, Hui Huang, Ruxuan Chen, Kai Xu, Mei Li, Xin Zhang, and Zuojun Xu. 2022. "Prognostic Analysis of Pneumocystis Jirovecii Pneumonia in Interstitial Lung Disease Patients: A Retrospective Clinical Study" Diagnostics 12, no. 12: 2925. https://doi.org/10.3390/diagnostics12122925
APA StyleSun, Y., Shao, C., Huang, H., Chen, R., Xu, K., Li, M., Zhang, X., & Xu, Z. (2022). Prognostic Analysis of Pneumocystis Jirovecii Pneumonia in Interstitial Lung Disease Patients: A Retrospective Clinical Study. Diagnostics, 12(12), 2925. https://doi.org/10.3390/diagnostics12122925

